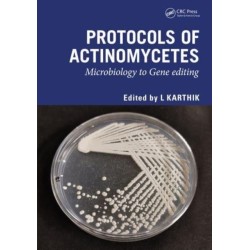
Protocols of Actinomycetes: Microbiology to Gene editing

Ingen varer
Sammenlignende religionsvidenskab igen
Der er 2+ underkategorier
Industriel kemi og produktionsteknologi
Visning: Type : Alle | Sprog : Alle | Format : Alle
-
Bemærk: Kan ikke leveres før jul.
Phytochemicals and Medicinal Plants in Food Design: Strategies and Technologies for Improved Healthcare (Bog, Paperback / softback, Engelsk)Discusses plant-based secondary metabolites for healthcare, focusing on the health aspects of herbs and medicinal plants and nutraceuticals for livestock production and for the treatment of diseases such as HIV and diabetes.
Levering: Skaffevare (forvent 14 - 30 hverdage) -
Bemærk: Kan ikke leveres før jul.
Food Processing and Preservation Technology: Advances, Methods, and Applications (Bog, Paperback / softback, Engelsk)Focuses on novel and nonthermal processing of food and food products, incluing dielectric heating and ohmic heating as well as three-dimensional printing of foods and ozonization of food products. It also delves into process interventions for food processing and preservations.
Levering: Skaffevare (forvent 14 - 30 hverdage) -
Bemærk: Kan ikke leveres før jul.
Materials Modeling for Macro to Micro/Nano Scale Systems (Bog, Paperback / softback, Engelsk)An overview of approaches for designing nanostructured materials. It covers several aspects of the simulation and design of nanomaterials. The... Læs mere
Levering: Skaffevare (forvent 14 - 30 hverdage) -
Bemærk: Kan ikke leveres før jul.
Biohydrogen: Developments and Prospects (Bog, Paperback / softback, Engelsk)Covers some the important recent advances in the production and utilization of biohydrogen and its solutions for clean fuel, waste management, waste valorization,... Læs mere
Levering: 6 - 9 hverdage -
Bemærk: Kan ikke leveres før jul.
Biomethane: Developments and Prospects (Bog, Paperback / softback, Engelsk)A comprehensive synopsis of the production and utilization of biomethane along with important recent advances. It covers the production of biomethane with emphasis... Læs mere
Levering: 6 - 9 hverdage -
Bemærk: Kan ikke leveres før jul.
Wool Sculpting: Needle Felting for Beginners (Bog, Hardback, Engelsk)With 10 beautiful step-by-step projects, master the art of needle felting with this practical guide.
Levering: 6 - 9 hverdage -
Bemærk: Kan ikke leveres før jul.
Model-Based Enterprise: Achieving Lasting Value with MBD and MBE (Bog, Hardback, Engelsk)Model-Based Enterprise describes Model-Based Enterprise (MBE) and Model-Based Definition (MBD) in detail, focusing on how to obtain significant business value from MBE.
Levering: 6 - 9 hverdage -
Bemærk: Kan ikke leveres før jul.
Protocols of Actinomycetes: Microbiology to Gene editing (Bog, Hardback, Engelsk)This book will cover basics to recent protocols for drug discovery from actinobacteria. It will be helpful for the pharmaceutical industries and researchers to develop new antibiotics from actinobacteria and would be used in support of future research in drug discovery.
Levering: Skaffevare (forvent 14 - 30 hverdage) -
Bemærk: Kan ikke leveres før jul.
Computational Techniques for Smart Manufacturing in Industry 5.0: Methods and Applications (Bog, Hardback, Engelsk)This work reviews recent advancements in research, new methods and techniques, and applications in computational techniques in intelligent manufacturing.
Levering: Skaffevare (forvent 14 - 30 hverdage) -
Bemærk: Kan ikke leveres før jul.
Tissue Culture Techniques and Medicinal Plants: Enhancing Propagation and Production (Bog, Hardback, Engelsk)This book describes the different methods of plant tissue culture that have been employed for the mass production of medicinal plants. The chapters on methods of organogenesis, embryogenesis, haploid plant production and more will be of interest to a wide range of readers.
Levering: Skaffevare (forvent 14 - 30 hverdage) -
Bemærk: Kan ikke leveres før jul.
Control of Heavy Metals in the Environment, Volume 1: Innovative Techniques and Solutions for Industrial Waste Treatment and Environmental Protection (Bog, Hardback, Engelsk)Offering broad coverage of basic and advanced principles and... Læs mere
Levering: Skaffevare (forvent 14 - 30 hverdage) -
Bemærk: Kan ikke leveres før jul.
Control of Heavy Metals in the Environment: Advanced Methods and Strategies for Heavy Metal Remediation and Environmental Protection (Bog, Hardback, Engelsk)Offering broad coverage of advanced principals and applications this book provides chemical and environmental engineers with the most complete resource available on remediation of heavy metal contaminants with an emphasis on advanced and alternative approaches.
Levering: Skaffevare (forvent 14 - 30 hverdage)

 for at udvide
kategorilisten.
for at udvide
kategorilisten.